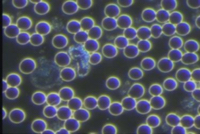

My Story of Dealing with Infectious Diseases and Medical Interventions
Conclusion
Purpose of this story is to help those who get overwhelmed by advice on what to do and do not know where to start. My message to you: “Just start anywhere and trust. Trust yourself, inner intelligence of your body and trust your journey. Focus on your next step.”
Whooping Cough
My husband Vasili got whooping cough, when he was a teenager. The disease developed complications and lasted 3 months. He nearly died. In spite of all medical treatments and drugs, Vasili got worse and worse by the day. Until one day an old-school doctor advised his mother to take him out of the hospital and to go to “change the climate”. Mom followed the advice and saved her son’s life: he miraculously recovered without a single pill. His system was quite messed up by the medical treatment and he was never the same for years.
We Just about Lost Our Baby!
You’d think my husband should have gotten life-long immunity to the whooping cough. Naturally. But this is not what happened. We were expecting our first baby Peter, when my husband got whooping cough – for the 2nd time in his life. This turned our world upside down, especially when we found out that if the baby gets the disease – 9 out of 10 chances he would die, as the new born baby’s immature lungs would not be able to cough up the phlegm.
Panicking, we both went on the required course of antibiotics. As a result, both of us felt very sick from the drugs. I had a lot of pain in my liver area. Luckily, the child did not get whooping cough. However, he was born jaundice and did not eat for nearly 24 hrs., no matter how hard I tried to get him to do so. Until a nurse noticed and brought us a breast pump and helped.
Raising a Child with Compromised Immunity
Growing up, Peter was a sickling, getting every cold and flu flying around and suffering with major digestive challenges and allergies. One time during a flu episode he went delirious, not understanding what he was saying or doing, which made me very scared. His body almost never ran a fever when he got a cold or flu, which may seem good to some, but I’ve learned that it is actually a sign of low immune system that is unable to fight. Needless to say, we had quite a few struggles and fears raising Peter. His immunity gradually has built up, but it took many years and sleepless nights.
When I Was Ready to Let My Child Die
But that was not the end of the story. When I was pregnant with our youngest son Michael, they found a bacteria in my birth channel. The doctor once again requested that I go on antibiotics, which I refused. He warned me that I was putting my child at risk -to which I responded that if the child is healthy and strong – he will overcome the bacteria, but if he is unhealthy, then I’d rather not have him born. It may seem harsh, but I knew what raising a sick child was like and made my decision without hesitation. The most handsome baby boy was born, alert, with a beautiful skin color, almost suntanned. The doctor let us out of the hospital after four hours. When the assisting nurse asked him in surprise, he answered: “This child is so healthy that I do not see any reason to keep them here”.
The family doctor afterwards admitted: I should not tell you that, but it was a good decision not to take antibiotics. Though I should admit I do not know what I would do myself in those circumstances.
Pressure to Get Treated
While in the hospital delivering Michael (I was there less than 10 hrs.), they offered me meds multiple times: oxytocin to induce the labour faster, epidural during labour contractions, pain killers after the labour pains, vitamin K injection to the baby and then taking his blood to testing for phenylketonuria. I let them inject the vitamin K, just to make them feel better, as they looked like their happiness depended on it, but refused everything else. There were a lot of attempts to convince and make me scared. “Meds cannot affect your baby, they won’t get to him.” Well, when I pumped my milk after drinking a green smoothie with my first child, it turned green – how can it not affect the baby?
From my understanding epidurals numb your feelings = the baby won’t feel the mother during that whole time, not understanding why and feel lonely. I also could not understand why after being able to deliver a baby naturally and having already gone through the most challenging part, I was offered to expose my child to chemicals by taking pain killers. And certainly I could not understand why they would inject vitamin K to ensure there are no blood clots formed and in the same time wanted to do a test on the phenylketonuria disease when the body cannot form those – as well as why they were so insistent to come to my home to do so? Wouldn’t two contradict to each other?
I could not understand why they would offer me oxytocin, knowing that wild contractions would start right away, causing discomfort, rapid birth, water loss and would forcefully move the baby out, instead of letting my body do it gradually and naturally. I was not even overdue! But most importantly, I could not understand why all babies had to go through these painful procedures without a substantial reason or indication that they needed it. Why should babies start their life with pain and feeling disconnected from their mom from their very first minutes of coming into this world? I could not understand why such obvious common-sense things were not obvious to medical professionals and why they routinely did the procedures that I would consider as needed only in case of an emergency. They even made me sign papers releasing them from responsibility if something were to happen, since I did not do some of those procedures.
Raising a Child with Healthy Immunity
Michael’s childhood was very different. He almost never got sick, and if he did – he simply would run a high fever, which I did not suppress and just gave him water and herbal teas regularly. He recovered every time within 24 hours, occasionally within 48 – without exception. If Michael ate something unhealthy, he would experience vomiting almost instantly. One day after a big supper at a hotel he vomited right in bed, another time it happened when we slept in a tent – by the way he continued sleeping in both cases as if nothing happened and could not remember next morning. One time, when this happened again, and after eating a bit too much at supper time, Michael vomited right on a trail as we were walking in a park, he asked: “Why is my body reacting in such a weird way?” We explained to him that his body is strong enough to react to things it does not want in or when he eats too much. Now Michael feels well with the amounts he needs and intuitively knows when he had enough.
Opting out of Vaccinations
There was one more area where we went against the medical grain. I was planning to take my oldest son for his first vaccination, when a friend of mine, who already had a few children on her own, said to me that she would not risk doing a vaccination for her child. I grew up in a regular family, did all vaccinations as per schedule and never thought much about it (except about the comment of a nurse who did a vaccine and shared with another one: she is such a tiny girl, she most likely will have a very difficult labour. Guess what: it was 4-5 hrs. long with both of them!) But coming back to the topic… I was afraid of not vaccinating because I never saw vaccination as a risk. I saw it the other way around.. But my friend insisted that vaccinations increase risk of autism in children. For some reason it made sense to me and I followed her advice. I also ordered a few books online about the topic and read them from the top to bottom. The books were very neutral and informative, but I got even stronger about my decision, as there were plenty of additional scientific facts backing it up. On top of it, when we moved, one of our neighbor who had an autistic granddaughter shared that she had a perfectly healthy grandchild before a vaccine. It was only after that the issues started. That rooted me even more, and I never looked back.
Chickenpox
When my children went to school, their friends did “chickenpox parties”. I did not participate in those. One day my son Peter’s best friend’s mother approached me: “You put our kids at risk by not vaccinating your child.” I was a bit surprised and did not say anything. Later, when her son and other close friend of Peter’s got chicken pox (both other were vaccinated), it was her turn to got surprised. Peter did not get it, despite the fact that the chicken pox is one of the most highly contagious viruses. She asked me what I did. I answered, ‘Instead of weakening his immune system with vaccines, every day I was working to strengthen it’ .
Discovering a Miracle Immune Booster, and Measles
My kids are just regular kids, and there were challenges along the way with raising both of them. They are neither disease proof nor totally immune. But I just put in my best effort whenever and wherever I could. For example, one year there were a lot of colds and flus in our family. As soon as one recovered, the second one started, then the third and fourth. As soon as one round was over, it started again. I do not know what caused it, but wanted to find answers.
Coincidentally, at that time I got Victoria Boutenko’s Book “Green for Life” about Green Smoothies. Writing the book, Victoria did an in-depth research on nutritional content of various greens. The book is full of interesting facts. From this book I’ve learned about the wild edibles (dandelion, lamb’s quarters, chickweed) and their benefits. I started studying more about these and learned that so called wild greens are much richer in minerals and other nutrients than their commercial green brothers (aka kale, spinach and lettuce). Additionally, I’ve learned that where there are more minerals, there are more enzymes and that enzymes really help to boost your immune system.
Peter was almost 2 years old, and Michael was just a month old baby, when I decided to visit my mom in Belarus (she could not get a visa). It was the biggest gift for her she’s ever received, as she described the trip later (while many Belarussian women said I was crazy to take such small kids abroad – they usually would not bring a baby in public until he/she was 3 months old). But it turned out to be a huge gift for me as well. I stayed in Belarus for 3 months. Since it was summer time, I picked fresh wild greens in the nearby forest to put into my green smoothies, adding wild berries and fruits that were in season. The aroma of fragrant fruit and berries totally neutralized green flavor, and I just packed those smoothies with every green edible thing I could find, from coltsfoot leaves, to stinging nettles.
Two things surprised me about smoothies. First of all, I noticed that the color of blueberries picked in wild never changed. It did not matter how long smoothies sat. While regular garden blueberries turn brown within an hour or two, the wild kind kept their color forever and even could colour smoothie in purple, if in large quantities! I found out that this is due to antioxidants, which are in wild blueberries in much higher quantities than in the garden ones… I remembered that my Belarussian friend got sick with measles, when she was twenty, in spite of being previously vaccinated. Measles led to her losing almost 100% of her vision. It was wild blueberry season, and my friend would go out to the forest next to her home, and find blueberries – by touch- and ate them all day long. She was able to restore her vision back to 100%!
Another interesting fact about the “wild smoothies” was that after drinking them (I could drink a litre or so at a time), I was totally not hungry for a very long time and could go without food for the entire day. Now this fully makes sense, as nutrient dense foods, such as the smoothie I was drinking, satisfy the body cells so quickly that they start sending a signal to the brain that no more nourishment is needed…
Making long story short – next year, after the wild smoothie summer no one in our family was sick – not even one day. If this was the case sometimes before, I would not take a notice. But this was such a drastic change. In the following years we continued with green smoothies from fresh greens from our own garden, and I found clean sources of wild greens when back home, too. Since then we stopped having colds and flus almost completely for at least few years. Even afterwards, the disease was very rare, mostly due to extreme high stress for Vasili and I. Since kids started being more and more influenced by other kids and eating unhealthy food, they started have occasional colds, but still very rarely and in those cases they recovered very well.
Overcoming Sore Throats and Runny Noses
We are both working parents, entrepreneurs. I am a Program Director facilitating health programs and cannot afford to get sick. So many things and people depend on me. By exception of a few very stressful times, I have never missed a day of work. It’s not because I was never exposed to or in contact with sick people, nor because I inherited very strong immune system. In fact, as a child I constantly had a running nose and sore throat. The doctors were planning to remove my tonsils due to the fact they started disintegrating – the only thing that prevented me to agree was that my mom just about died due to bleeding during the same surgery. I used to walk with handkerchief all my teenage years and had pharyngitis every school year. I thought that it was normal. Now I never carry handkerchief and rarely get sore throat. I have had a few colds once and a while over the years, but in most cases they did not last more than 3 days. I probably, could have been without them completely, but life was full of stresses and life challenges (like most of you reading this), so I didn’t always looked after myself well.
Secret to a Flu-Free Life
I found a way to get over any sickness that occasionally came my way. Whenever I feel I might be coming down with a cold, I do a thorough digestive cleanse, as well as some fasting or semi-fasting. Instead of being sick for weeks, I get over a cold within days – if I start early enough I will not get sick at all.
How does it work? A cold is your body’s way to eliminate accumulated toxins. Viruses and bacteria feed on toxins. When we assist the body with toxin removal, firstly, we remove the need for the body to do it itself via fever and runny nose; secondly, we allow the body to rest and help cells accumulate energy; and thirdly, we remove the viruses’ food supply, which is needed for them to multiply. There are, of course, many other simple methods you can use to assist the body in recovery, but detox is the main one.
Another Dirty Secret of Being Flu-Free
Another thing I’ve learned is that large consumption of animal products, and actually all cooked foods, lead to excessive mucous production. Avoiding or cutting down on those may significantly lower incidences of flues and colds, runny noses and sore throat. When the body gets large quantities of foods that it cannot digest effectively, it’ll start producing mucous as a protective measure, to trap the ingredient it cannot digest in hopes to be able to eliminate it later.
There are many studies that will assure you that milk does not cause increase in mucous, but from my childhood experience I can say the opposite. Belarus is a milk and bread country. These two products are consumed on a daily basis, in copious amounts, as the basis of most snacks and even meals. Runny noses and sore throats are very common, much higher than what I observe in Canada. Before I came here, I thought it was a normal part of life!
However, since I have significantly cut down my dairy consumption, I do not experience any of the past symptoms. But just as soon as I start eating more breads and dairy again – the symptoms return shortly. There are a few reasons why dairy is highly mucous-forming. First, most adult people cannot digest milk well, due to lack of the enzyme called lactase. Secondly, most dairy available in the store included artificial ingredients (f. ex. milk ingredients and therefore is rejected by the body (milk powders, fillers, preservatives, hormones etc.).
Conclusion
When I started writing this story, I did not realize how much modern medicine and the world of viruses and bacteria affected my life and family. In the process of it all, we were just resolving simple life situations that most of you come across. Looking back, I see how the answers always gradually came, when questions were sent to the Universe (or God?), as well how we gradually learned what immune system is and how to help it work more effectively. Looking ahead, with full realization of the world we are living in, I live in peace, knowing that so many more things are in our hands than not. That there are solutions out there, and if we as individuals or society need more of them, they’ll come – as long as we are ready to keep our eyes and minds open, as long as we are interested in working on improving our health and ourselves. There are no magic pills or quick solutions, but there is always an accumulative result of long-term effort.
References/Additional Reading:
[i] Book “Green4Life”, by Victoria Boutenko
[ii] Research on Enzymes and Immunity Connection
[iv] Book “Vaccinations: A Thoughtful Parent’s Guide: How to Make Safe, Sensible Decisions about the Risks, Benefits, and Alternatives”, by Aviva Jill Romm
DISCLAIMER: This article is a personal story and does not have a goal to provide a medical advice. If you have compromised immunity or other health conditions, please consult a physician and use your common sense about what would be safe and beneficial for you.
About the Author: Ania Kastashchuk
Ania Kastashchuk is the Program Manager, Senior Program Director and Co-Founder of Fresh Start Health Retreat, specializing in health restoration using natural health methods. Fresh Start is located on Vancouver Island, BC, Canada. The retreat focuses on 4 areas: Detox & Recharge, Physical Health, Emotional Wellness and Habits Re-patterning (quit smoking, mild social drinking, emotional eating). Over the last 15 years Ania with her husband Vasili and team of professionals have been assisting those who are ready for a change to transform their health and lifestyle naturally.